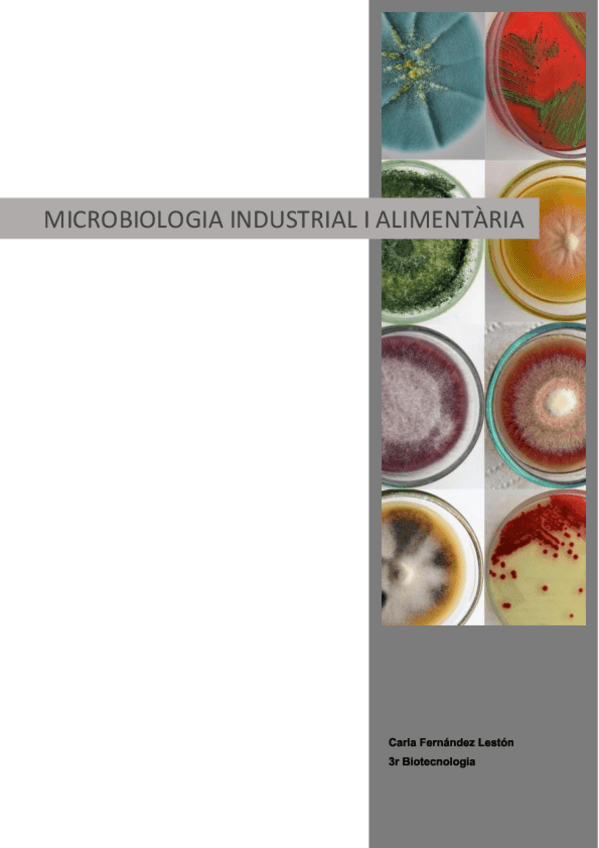

Microbiologia Industrial i Alimentària
He publicado nuevos apuntes de 3º Microbiologia Industrial i Alimentària: Tema-15-MIA.pdf
He publicado nuevos apuntes de 3º Microbiologia Industrial i Alimentària: Tema-14-MIA.pdf
He publicado nuevos apuntes de 3º Microbiologia Industrial i Alimentària: Tema-13-MIA.pdf
He publicado nuevos apuntes de 3º Microbiologia Industrial i Alimentària: Tema-12-MIA.pdf
He publicado nuevos apuntes de 3º Microbiologia Industrial i Alimentària: Tema-11-MIA.pdf
He publicado nuevos apuntes de 3º Microbiologia Industrial i Alimentària: Tema-10-MIA.pdf
He publicado nuevos apuntes de 3º Microbiologia Industrial i Alimentària: Tema-9-MIA.pdf
He publicado nuevos apuntes de 3º Microbiologia Industrial i Alimentària: Tema-8-MIA.pdf
He publicado nuevos apuntes de 3º Microbiologia Industrial i Alimentària: Tema-7-MIA.pdf
He publicado nuevos apuntes de 3º Microbiologia Industrial i Alimentària: Tema-6-MIA.pdf
He publicado nuevos apuntes de 3º Microbiologia Industrial i Alimentària: Microbiologia-industrial-TOT.pdf
APUNTS BREUS MICRO INDUSTRIAL I ALIMENTÀRIA
He publicado nuevos apuntes de 3º Microbiologia Industrial i Alimentària: Tema-5-MIA.pdf
He publicado nuevos apuntes de 3º Microbiologia Industrial i Alimentària: Tema-4-MIA.pdf
He publicado nuevos apuntes de 3º Microbiologia Industrial i Alimentària: Tema-3-MIA.pdf
He publicado nuevos apuntes de 3º Microbiologia Industrial i Alimentària: Tema-2-MIA.pdf
He publicado nuevos apuntes de 3º Microbiologia Industrial i Alimentària: Tema-1-MIA.pdf
He publicado nuevos apuntes de 3º Microbiologia Industrial i Alimentària: MIA-Apuntscompressed.pdf
He publicado nuevos apuntes de 3º Microbiologia Industrial i Alimentària: resum.pdf
He publicado nuevos apuntes de 3º Microbiologia Industrial i Alimentària: MIA-para-imprimir.pdf
He publicado nuevos practicas de 3º Microbiologia Industrial i Alimentària: Apuntes-practicas-MIA.pdf
He publicado nuevos apuntes de 3º Microbiologia Industrial i Alimentària: APUNTS-MIA.pdf
He publicado nuevos apuntes de 3º Microbiologia Industrial i Alimentària: MIA-Primera-parte-microbiologia-industrial.pdf
He publicado nuevos practicas de 3º Microbiologia Industrial i Alimentària: PRACTIQUES-MIA.pdf
He publicado nuevos apuntes de 3º Microbiologia Industrial i Alimentària: 8-Microbiologia-alimentaria.pdf
He publicado nuevos practicas de 3º Microbiologia Industrial i Alimentària: PRACTIQUES-MIA-.pdf
He publicado nuevos practicas de 3º Microbiologia Industrial i Alimentària: practicas-mia.pdf
He publicado nuevos apuntes de 3º Microbiologia Industrial i Alimentària: Apunts-MIA.pdf
apuntes
-
Microbiologia Industrial i Alimentària
He publicado nuevos apuntes de 3º Microbiologia Industrial i Alimentària: Microbiologia Industrial i Alimentària

¡Estás al día!
Has visto todos los archivos